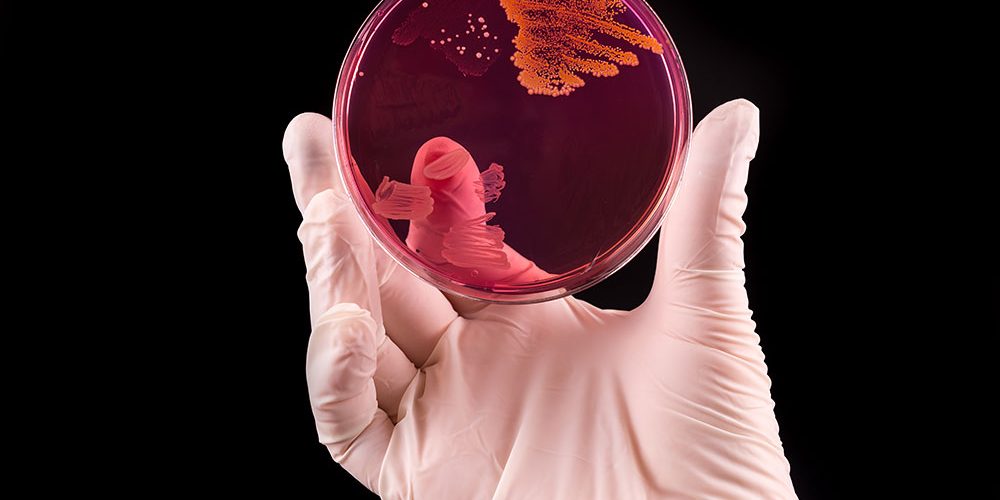

The surfaces of intravascular catheters can rapidly become coated with a patient’s matrix proteins, to which staphylococci proteins could then bind themselves. Treating these infections effectively still represents a significant clinical challenge, and the most effective agent against them has yet to be determined. Although the broad antimicrobial properties of Citrox against a range of pathogens have already been established,[i] research has not included staphylococci or in vivo experiments. A 2016 study[ii] at the Department of Microbiology at Dublin’s Beaumont Hospital has demonstrated the natural bioflavonoid as a valid agent against in vivo catheter-related infections involving Staphylococcus aureus biofilms.
The need for a novel antimicrobial
To start with, there are a few methods to treat staphylococcal catheter infections. The first one is to simply remove the catheter, but this is not always possible owing to clinical circumstances and could actually endanger the patient’s health. A second method is giving the patient systemic antibiotics. Systemic antibiotics are the usual choice for treating catheter-related infections, but although they are effective in eliminating circulating planktonic bacteria, they generally fail to sterilise the catheter itself, leaving the patient at risk of complications or recurring infection. Lastly, with a catheter-locking solution, a high concentration of an antimicrobial is applied at the site of the infection, but unfortunately, a large number of antibiotics and antiseptic agents are not effective when used as catheter-locking solutions for the treatment of biofilm mediated S. aureus infection. In other words, there is an urgent need for a novel and effective treatment agent.
Citrox: A best practice
During their in vitro study, the Beaumont Hospitalresearchers found Citrox concentrations as low as 1 per cent to be optimal for the inactivation of S. aureus bacterial cells in both static and flow conditions. This is significant, as staphylococcal biofilms under flow conditions have previously been shown to be more tolerant to treatment than those formed under static conditions.
“No resistance to Citrox arose in the tested strains over a period of 90 days. In contrast, bacterial resistance to antibiotics has been reported after two to five days.”
So far, treating patients with conventional antimicrobials against staphylococcal biofilm infections has often failed owing to the antimicrobial resistance of organisms within the biofilm and because the antimicrobial agents failed to reach a desired minimum inhibitory concentration within this environment. During the study’s in vitro and in vivo tests, Citrox was able to kill biofilms formed over one, three and five days at the very low concentration of 1 per cent. No resistance to Citrox arose in the tested strains over a period of 90 days. In contrast, bacterial resistance to antibiotics has been reported after two to five days.
Further possibilities
The anti-staphylococcal biofilm properties of Citrox are reported for the first time in the Beaumont Hospital study. As such, it is the first to prove Citrox’s potential for treating catheter-related staphylococcal biofilm infections. The therapeutic use of Citrox could be extended to other S. aureus models of infection such as prosthetic joints, but also within oral health care for surgical site infections and wound infections.
 A study at Dublin’s Beaumont Hospital has found Citrox to be a valid agent against catheter-related infections involving Staphylococcus aureus biofilms. The therapeutic use of Citrox could be extended to treating S. aureus infections in prosthetic joints, but also within oral health care for surgical site infections and wound infections. (Photograph: Shutterstock/Zaharia Bogdan Rares)
A study at Dublin’s Beaumont Hospital has found Citrox to be a valid agent against catheter-related infections involving Staphylococcus aureus biofilms. The therapeutic use of Citrox could be extended to treating S. aureus infections in prosthetic joints, but also within oral health care for surgical site infections and wound infections. (Photograph: Shutterstock/Zaharia Bogdan Rares)
[i] Hooper SJ, Lewis MA, Wilson MJ, Williams DW. Antimicrobial activity of Citrox® bioflavonoid preparations against oral microorganisms. Br Dent J. 2011 Jan 8;210(1):E22. doi: 10.1038/sj.bdj.2010.1224.
[ii] Hogan S, Zapotoczna M, Stevens NT, Humphreys H, O’Gara JP, O’Neill E. Eradication of Staphylococcus aureus catheter-related biofilm infections using ML:8 and Citrox. Antimicrob Agents Chemother. 2016 Sep 23;60(10):5968–75. doi: 10.1128/AAC.00910-16.